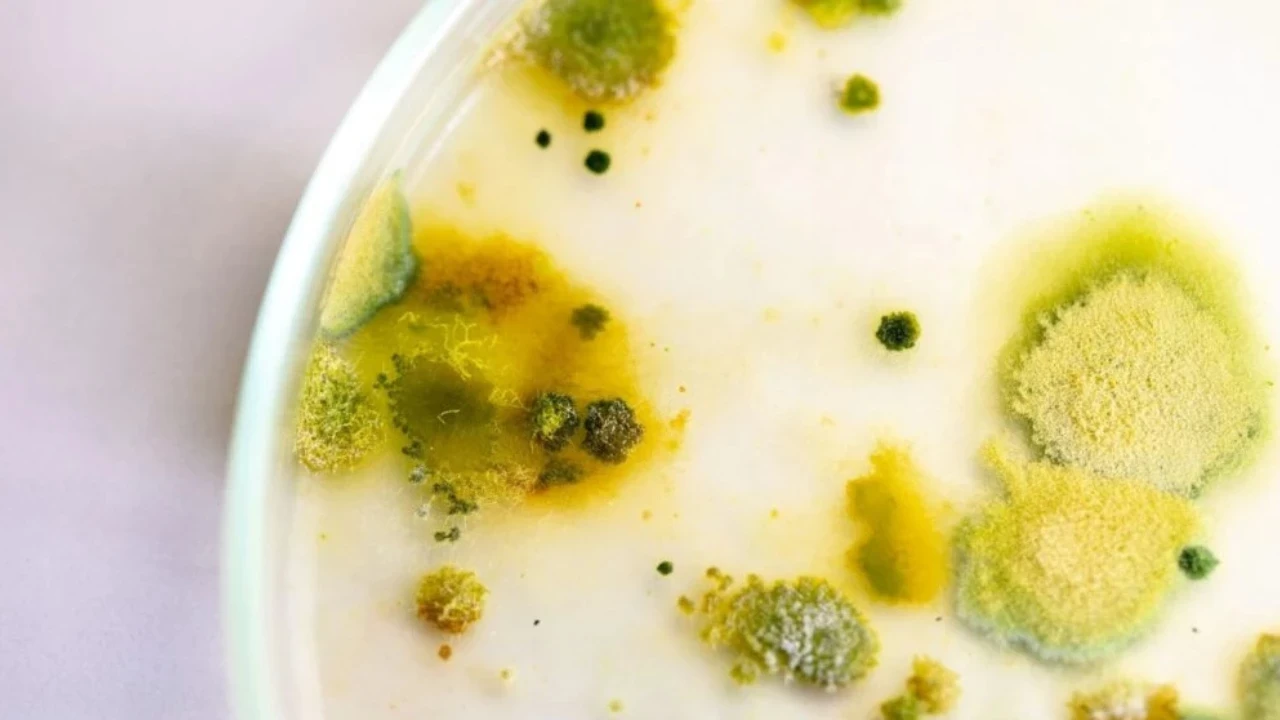
Küflenmiş yoğurt maskesinin faydalarına inanamayacaksınız!

Cilt bakımında alışılmışın dışında bir uygulama daha konuşuluyor: Küflenmiş yoğurt maskesi! İlk duyduğunuzda şaşırabilir, hatta endişe duyabilirsiniz; ancak sosyal medyada hızla yayılan bu yöntem, geniş gözenekler ve solgun cilt sorunu yaşayanlar için doğal ve etkili bir alternatif olarak öne çıkıyor. Gerçekten fayda sağlıyor mu? İşte ayrıntılar…
KÜFLÜ YOĞURT MASKESİ NEDİR?
Küflenmiş yoğurt, aslında son tüketim tarihi geçmiş ve üst yüzeyinde yeşil veya mavi tonlarda küf tabakası oluşmuş yoğurt anlamına gelir. Cilt bakımında kullanılan kısım ise, bu küflü tabakanın hemen altındaki yoğurt bölümüdür. İçeriğindeki probiyotikler, laktik asit ve doğal fermente bileşenler sayesinde, bu yoğurtlar cilt üzerinde doğal bir peeling etkisi yaratır.
Fakat uzmanlar, burada çok önemli bir uyarıda bulunuyor: Küf tabakası değil, yalnızca altındaki yoğurt kısmı kullanılmalıdır. Ayrıca maskeyi cilde uygulamadan önce, küçük bir bölgede alerji testi yapılması tavsiye edilir.
SİVİLCE VE AKNEYLE MÜCADELEDE DOĞAL DESTEK
Yoğurt, antibakteriyel ve antifungal etkileriyle bilinen doğal bir besindir. İçerdiği laktik asit sayesinde ciltte biriken ölü deriyi nazikçe arındırırken, probiyotikler zararlı mikroorganizmaların çoğalmasını engeller. Bu nitelikleriyle yoğurt maskesi, sivilce ve akne oluşumunu azaltmada fayda sağlayabilir.
Küflenmiş yoğurt maskesi ise, özellikle akneye meyilli ciltlerde sebum üretimini dengeleyerek, iltihaplanmaları hafifletebilir ve yeni sivilcelerin ortaya çıkmasını önleyebilir. Yine de, maskeyi kullanmadan önce cildinizin küçük bir bölgesinde deneme yapmanız önemlidir.